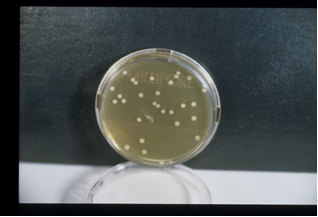

TBA Tryptone Bile Agar, medio de cultivo sólido para la detección y recuento confirmativos de Escherichia coli en aguas según ISO 9308-1
Medio para la detección y recuento confirmativo de Escherichia coli en aguas, por el método de Filtración de Membrana, mediante ensayo rápido según Norma ISO 9308-1:2001, BOE 45 de 21/2/2003 de aguas de consumo humano y BOE 259 de 29/X/2003 de aguas de bebida envasadas.
COMPOSICIÓN
- Triptona 20,0 g
- Sales Biliares 1,5 g
- Agar-Agar 15,0 g
(Fórmula por litro)
pH final: 7,2 ± 0,1
PREPARACIÓN
Disolver 36,5 g de medio en 1 litro de agua destilada. Calentar agitando hasta ebullición. Repartir en envases de menos de 250 ml. Autoclavar a 121 ºC durante 15 minutos.
Enfriar a 55°C aproximadamente y verter en placas formando una capa de espesor no inferior a 5 mm.
PARA USO EXCLUSIVO EN LABORATORIO. MANTENGA EL BOTE BIEN CERRADO EN LUGAR SECO, FRESCO Y OSCURO. AGITE EL BOTE ANTES DE USAR.
PRESENTACIÓN: DESHIDRATADO CODIGO: DMT135. MEDIO COMPLETO PREPARADO EN PLAQUIS ® HERMÉTICAS MF: PPL914. FRASCOS PREPARADOS.
PARA USO EXCLUSIVO EN LABORATORIO.
MANTENGA EL MEDIO PREPARADO A 15-21°C, EN TOTAL OSCURIDAD.
CONTROL DE CALIDAD DEL MEDIO
Realizado en nuestro laboratorio; es prudente repetirlo en su laboratorio siempre que varíen las condiciones (más de 3 meses sin usar, tras desinfectar el laboratorio, tras conservar a alta Tª por fallos de refrigeración, cuando adquiere aspectos extraños aunque no haya llegado la fecha de caducidad teórica de su etiqueta…)
DESHIDRATADO: Polvo crema. PREPARADO: Agar crema, homogéneo, traslúcido.
CONTROL DE CRECIMIENTO 18-48 h a 44°C aproximadamente:
- E.coli MKTA 25922, Crecimiento correcto, colonias rojas tras la prueba del indol a 44°C. Con respecto a PCA estandarizado,* recuento 95-150 %, pero de forma selectiva.
- Klebsiella oxytoca MKTA 13182, Crecimiento correcto, nunca colonias rojas tras la prueba del indol a 44°C. Con respecto a PCA estandarizado,* recuento 141 %, pero de forma selectiva.
- Staphylococcus aureus MKTA 6538P, inhibido.
* El que cumple con recuperación superior al 92-125% con respecto a cepas cuantitativas trazables a la cepa tipo. Incertidumbres detectadas entre todos los lotes a lo largo de un año (la mayoría de la incertidumbre se debe a la cepa y a la proporción de cepas acompañantes inoculadas, no al medio).
MODO DE EMPLEO E INTERPRETACIÓN DE RESULTADOS
Sembrar la membrana filtrada (procedente de incubación de 4-5h a 34-38 °C, en TSA) evitando la formación de burbujas entre el filtro y el medio. Incubar 19-20 horas a 44 ± 0,5 °C.
Colocar la membrana sobre un cartón saturado en reactivo de Indol Kovacs (SBH056) e irradiar con luz ultravioleta entre 10 y 30 minutos. Se cuentan todas las colonias rojas, considerándolas como E.coli.
El usuario final es el único responsable de eliminar los microorganismos de acuerdo con la legislación medioambiental vigente. Autoclavar o inundar en lejía antes de desechar a la basura.
Si desea más información sobre nuestro T.B.A. Tryptone Bile Agar rellene nuestro formulario de contacto http://www.medioscultivo.com/contacto . O si lo prefiere póngase en contacto con nosotros a través de nuestro correo electrónico microkit@microkit.es o por teléfono en el nº 91-897 46 16